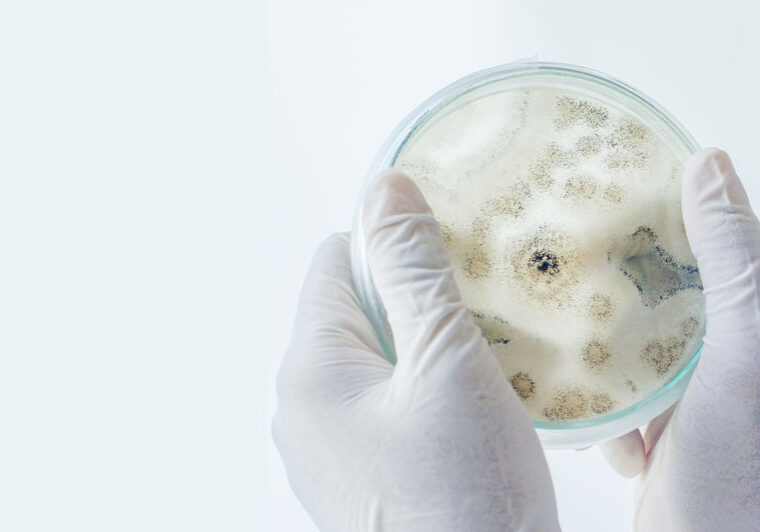
Mould Inspection by Adelaide mould expert - Assessment, sampling and lab report - 25+ years experience

Asbestos Inspections, Testing and Labs
Comprehensive service from material identification to expert opinion.
Inspection, register reporting, risk assessments, sampling, monitoring, and remediation advice.
Mould Inspection and Assessments
Site inspection to assess conditions, including surface and air sampling in water damaged buildings
Lab testing with risk guidance and recommendations
Post remediation verification
Water Damaged Buildings, Flooding and Waste Water Assessments
We provide investigation into moisture intrusion, plumbing failures, waterproofing issues, flood and mould assessments.
Occupational Hygiene Assessments
Forensic testing and remediation action plans
Noise assessments
Indoor air quality surveys
Respirable/inhalable dust surveys
Hazardous Materials Inspections and Reports
Assess and reduce risk
Pre-demolition surveys to identify hazmat such as lead, polychlorinated biphenyls, synthetic mineral fibres, ozone-depleting substances, radioactive isotopes, mercury and asbestos.
Silica Assessments and Air Monitoring
Silica assessments involve air monitoring to measure dust levels.
Air monitoring helps determine workplace exposure.
Ascertain if adequate controls are in place to mitigate silica-related health issues.
Imported Goods, Customs Inspection and Testing
Inspection of vehicles, trailers and general building materials imported to Australia that require assessment for suspect asbestos products.
Illicit Drug Surveys, Sampling and Labs
Methamphetamine property screening
Illicit drug property screening and contamination investigation
Clandestine drug lab and associated contamination assessment
Forensic testing

Contact Andrew Butler,
Licenced Inspector for Asbestos, Hazardous Materials
and Customs Inspections.
25 years experience
Mobile
0476 943 768